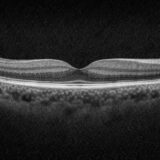
CIRRUS OCTのGanglion Cell解析を徹底解説|GCL+IPLの意味とレポートの見方

TSASって何?なんで連続撮影?なんで乱れる?

【眼科検査機器】トーメーMR-6000とニデックTONOREFⅢPlusを徹底比較|レフケラ選びの決定版!

CIRRUS OCTのPanoMap解析とは?構成・見方・特徴を徹底解説

ETDRSグリッドって何?──眼科OCTレポートでよく見るアレの正体

20250608営業職の僕が髭脱毛を6回受けて実感した効果|1年間のリアルな経過と変化

OCTとは?解析レポートの見方と活用ポイントを解説

【最新機能まとめ】ニデック社TONOREFⅢPlusとは?レフ・ケラト・トノ・アコモ測定が1台で完結!
CIRRUS OCTのGanglion Cell解析を徹底解説|GCL+IPLの意味とレポートの見方

0.5ミリ先 


